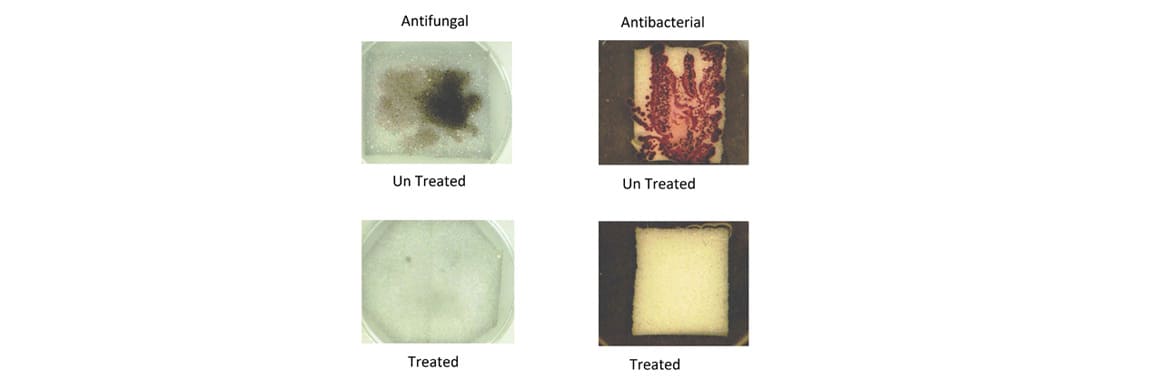

In the automobile industry, polyether polyurethane foam finds various applications. Although seating is one area which is readily identifiable automotive PU Foams main function is to reduce noise, vibration and harshness, thereby enhancing the automotive performance. These foams, often called NVH (Noise Vibration and Harshness) foams, are part of the Springfeel polyurethane foam range.
Automotive foam uses include door panels, roof linings, steering wheels, passenger shell sound insulation, engine area thermal insulation, carpet underlay, vibration dampening of the transmission column, dash boards, bumpers of cars, etc. They also absorb and isolate noise and vibration, and protect vital cables and wiring. The density of foam and the grade used in automobiles varies depending on the primary purpose of the component in which it is used.
In automotive industry, the physical properties of PU foam can dampen vibration and noises absorption which cause the discomfort in travelling. With these applications, PU foam widely being used for “Motor Encapsulation, Under Seat and Dashboard”
Some special foam with water/air sealing properties is used in air and water seal for air conditioning system for vehicles. Besides, PU foam also can produce to be seat cover after fabrication process. Hard PU foam has closed cell structure and hence it has excellent insulating properties. Car roof linings and Sun Visors are some of other applications.
Springfeel’s automotive foams meet every quality parameter, as each foaming is laboratory-tested for density, tensile strength, elongation, hardness and compression set and flammability.
Springfeel’s automotive foam has a regular and fine cell structure and has excellent mechanical strength and is not affected by organic solvents and petroleum products. This foam complies to FMVSS-302 standards with a burn rate of ≤ 100 mm/min. This foam is a perfect medium for flame and adhesive laminations with various normal and technical textiles.
The Main Applications
Seat Cover.
Cushion overlay (Fabric backing).
Door panels.
Sound absorption and vibration dampening.
Dashboards & Sunvisors.
Steering wheels.
Energy absorbers.
Headliners.
Airbag covers.
Window encapsulation.

Springfeel flexible polyurethane foam is having anti-static properties finds application mainly in the field of packaging of high cost electronic components which require protection from discharge of static electricity build-up while in transit.
Springfeel’s Anti-static foam provides controlled, dissipation of electro-static charges emitted from other adjacent materials and personnel’s during material handling, assembling and shipment of the product. Our anti-static foam, provide long term RELIABILITY of anti-static performance and protection for the packed materials.
For Flexible polyurethane foam materials intended to dissipate electrostatic charges, surface resistivity of the product is the most common measurement of a material’s ability to do so. It is measured by using ohm meter.
Features Of Antistatic Foam:
Static dissipative polyurethane 10 to the power 11 ohms.
Antistatic low charging – minimizing electrostatic charge generation.
Provides protection from physical shock during handling, packaging, shipping, and storage of ESD sensitive devices.
Ideal for short term use.
Easy to adapt for custom uses by die-cutting, laminating, etc.
Non-contaminating and non corrosive
The Main Applications
Transportation of Electronic Goods.
Medical beds used in Hospital.
Equipments used in dental clinics. (Examination Chairs)
Technical Specification
The open cell structure of Acoustic Foam allows absorption of airborne sound by dissipating the energy within the cellular network, leading to the highest level of noise reduction. Springfeel’s acoustic foam products in a range of different densities, grades and thicknesses. Whatever type of Acoustic Foam product you want, we are confident that we can manufacture it.
All polyurethane foam can’t be used for acoustic purpose. Since Springfeel’s acoustic grade foam is specifically engineered and it has a homogeneous and consistent cell structure it can be effectively used in acoustic applications. Springfeel offers a wide range of acoustic insulation products specifically designed to absorb and reduce noise and vibrations.
Acoustical foam’s effectiveness is measured by its Noise Reduction Coefficient, or NRC rating as per ASTM C423 /ISO 354 standard. Noise Reduction Coefficient (NRC) is given by the average value of sound absorption coefficient at 250 Hz, 500 Hz, 1000 Hz and 2000 Hz.
Springfeel’ acoustic foam has good sound absorption properties with a NRC (Noise Reduction Coefficient) value up to 0.8 and hence it is used in many industries like Automotive, Power generation, Construction and HVAC. Springfeel’s acoustic foam can be supplied in various types such as plain sheets, rolls or special shapes like pyramids, wedges, egg tray by using CNC profile cutting machine. They work not only to absorb sounds, but also to enhance the quality of sound and speech in a room.
Since the polyurethane foam is insoluble with a high ignition point and a high-temperature range. It can be incorporated in composites with a self-adhesive backing and it acts as polymeric anti-vibration layer.
Advantages of Springfeel Acoustics Foam
Cancels mid and high-level noise, also known as ‘slap echo’.
Minimizes ambient noise in a room.
Guaranteed to improve the acoustic levels of any room.
Springfeel open-celled special technology polyurethane foam has distinctive features and high sound absorption properties making it ideal for studios, cinema and theatres, and can be applied also to offices, warehouses, manufacturing plants and generator set area.
The Main Applications
Auditorium.
Theatres.
Conference Hall.
Automotive.
HVAC.
Audio & Video recording studio.
Generators & Air Compressors shields.
Noise reducers for industrial application.
Motor testing rooms.
Technical Specification
Since polyurethane foam is used extensively in home furnishing, comfort and automotive segments it is important that the finished product should be protected from bacteria because in PU foam there is wide scope for micro organism to dwell and grow. This bacteria and fungi can cause odor, stains and degradation. Since dust mites are often found in furniture cushion and mattresses it becomes imperative to add antimicrobial agents in the foam
Anti microbiological foam from Springfeel effectively limits the bacteria and provides protection against the harmful bacteria. Microbiological test performed on the antimicrobial foam from Springfeel shows significant decrease in the number of micro-organisms.
An antimicrobial is an agent that kills micro organisms or stops their growth. Our antimicrobial is a line of Zinc Pyrithione specifically designed to protect polyurethane foam from degradation, malodors and staining caused by fungi and bacteria. We are using Milliken brand antimicrobial dispersion called “AlphaSan” for Antifungal and Antibacterial Dispersion in Polyurethane foam.
AlphaSan AF Dispersion
High efficacy against fungi & bacteria.
Stable dispersion.
Easy to re-disperse.
Permits antimicrobial claims.
Technical Specification
Springfeel’s Fire Retardant special foams are formulated in a way which not only slows down the burning rate of foam but also get self-extinguished. Springfeel offers FR foam in various densities with various FR standards like CAL – 117, UL-94 HF1, BS-5852, FMVSS-302 and IS-7888 international and domestic test standards by a significant mark.
Flame Retardants Are Categorized As Either Additive or Reactive.
Additive flame retardants are incorporated into the compounds via physical mixing. Compounds containing flame-retardant elements are mixed with existing polymers without undergoing any chemical reactions. As a result, the polymer/additive mixture is less susceptible to combustion than the polymer alone. Since additive flame retardants can be incorporated into the product up until the final stages of manufacturing, it is typically simpler for manufacturers to use additive flame retardants than reactive flame retardants.
Reactive flame retardants are incorporated into polymers via chemical reactions. Reactive flame retardants must be incorporated at an early stage of manufacturing, but once introduced they become a permanent part of the polymer structure. Once they are chemically bound, reactive flame-retardant chemicals cease to exist as separate chemical entities. Reactive flame retardants have a greater effect than additive flame retardants on the chemical and physical properties of the polymer into which they are incorporated.
Springfeel uses non-halogenated phosphate Additive flame retardants. It demonstrates superior long-term efficacy as compared to chlorinated phosphate esters by virtue of its lower volatility upon ageing.
During combustion, the phosphate forms a char layer on the surface of the foam, acting as an insulator for the remaining material. The char layer acts as a barrier between oxygen and polymeric decomposition gases. There is convincing evidence, that in oxygen-containing polymers, phosphorous containing flame retardants can increase the char yield. Char formation implies that less of the molten polymer substrate is converted to combustible gases, so the mass loss is reduced. Secondly, char formation is often accompanied by water release, which dilutes the combustible vapours, making the vapours less combustible.
Springfeel Fire Retardant Foams Offer The Following Advantages
Low volatility and low discoloration and are used to allow manufactures to clear the FR standards like CAL – 117, UL-94 HF1, BS-5852, FMVSS-302 and IS-7888 international and domestic test with ease.
Low emissions/fogging in foams.
Superior foam physical properties.
Excellent ageing retention, maintains FR performance over time.
Excellent lamination properties.
The Main Applications
Automotive Industry. (Car seat cover/sunvisors).
Chair Seat & back Cushion in Made ups.
Acoustic application.
Used in Diesel Generators.
Furniture Cushions.
Technical Specification
Polyurethane, the product of choice in shoe soling, is now being used in a greater number of footwear applications. Much of that increase is due to advances in polyurethane systems for shoe sole application. These systems provide improved comfort and abrasion resistance
Polyurethane also has a low density in shoe soles, resulting in a lighter weighing shoe. In footwear, foam is used in the form of insoles to give a better fit to the shoes. In sports shoes especially, foam is used to provide cushioning and protection.
Springfeel is a leading manufacturer and creates a niche of polyurethane foam for shoes, such as Shoe Midsole, Sports Shoes, Shoe Bottom and Shoe Upper which meets international standards and quality. They provide excellent long-term mechanical properties and they are flexible, comfortable and easy to wear.
Springfeel makes special foot wear grade foams such as UV foam, Soft foam and Hard foam.
Springfeel’s Polyurethane foams haves stronger cell walls which bounce back quickly after compression and doesn’t lose its ‘rebound’ after repeated use.
The Major Applications
Sports Shoes.
Running Shoes.
Safty Shoes.
Technical Specification
Springfeel Hypersoft foam is a super soft, supple foam developed for home furnishings applications. The improved tear strength and permeability of Hypersoft is a fusion of luxury, durability and comfort.
Hypersoft foam is used as one of the top layers on many premium mattresses. It is also exceptionally breathable, providing ventilation that helps you stay cooler in the summer and warmer during the cold months.
Hypersoft foam holds the shape for a longer period and due to this effectively competes with polyester fillers.
The Main Applications
Mattress Quilting.
Pillows.
Mattress Toppers.
Technical Specification
The inherent open cell structure of flexible foam helps to absorb fluids.This characteristic can be combined with different properties of foam like density, hardness, cell structure and hydrophilic qualities to develop high quality hydrophilic foam. These special grades of foams are used for washing, wiping, moping, scrubbing and polishing.
Springfeel’s Hydrophilic polyurethane foam with its excellent fluid handling characteristics is ideal flexible foam for a broad range of applications throughout many industries. It has various properties such as efficient absorbency, durability and strength which make the product an excellent choice as an applicator, wicking pad and sponges. Its hydrophilic properties ensure full absorption of solvents and fluids, ensuring both minimal wastage when used as an applicator and for wicking, this will absorb up to 15 to 20 times of its weight in fluids.
It’s also used as packaging for moisture sensitive goods like silicon wafers in semi-conductor manufacturing.
The Main Applications
Sponge foam for body care & household.
Packaging for moisture sensitive goods.
Cushions for outdoor/marine applications.
Foam for diapers.
Ink cartridges.
Consumer goods.
Technical Specification
Springfeel’s hard foam is the most preferred foam for applications which requires higher load bearing capacity and hardness. Due to this extra hardness it can be easily processed for various die cut shapes for automotive parts like sunvisors, door panels etc.
This hard foam can be laminated with other substrates efficiently.
Hard foams are specially used in various parts of the footwear.
Additionally, hard foams have good acoustic damping properties; therefore it can be used in genarators and refrigerators.
The Main Applications
Footwear.
Automobile industry.
Saddles.
Skating Pads.
Sports Goods.
Technical Specification
HR foam or High Resilience foam is one of the most superior grades of PU foam. Increased elasticity and good tensile strength makes high resilience foam a preferred grade in Home furnishing and mattress segment.
Since it has good elastic property it prolongs the life of the mattress, higher the resilience in the foam will lead to better comfort and longevity of the mattress.
HR-foam is mostly used for manufacturing of comfortable furniture and high end mattresses. We make HR-foam in 32 & 40 kg/m3 with good load bearing properties and at the same time it provides extreme comfort.
The low cost of high resilience foam compared to the high cost of latex foam, makes the price of bedding products affordable without compromising the products comfort level.
The Main Applications
Premium foam mattresses.
Mattress Toppers.
Orthopedic Mattress.
Furniture.
Upholstery.
Technical Specification
Different types of PU foam can be used for lamination. Depending on raw materials the final product might be applied in various industries including Footwear, Furniture, Automotive industry etc. Double and triple layer materials are mostly applied because they ensure a lot better appearance, durability and sound proofing properties of a product. Based on the application of the final product, the substrate such as a PU film, Fabric, or any other PU material can be chosen.
The lamination of foam to different substrates is either achieved by using adhesive lamination or flame lamination.
In adhesive foam lamination, as the name implies, adhesives are used to attach the foam to the substrate. During adhesive lamination, the foam is laminated using bonding agents, such as pressure sensitive adhesive (PSA). Agents may be applied directly onto both surfaces, or they may be applied indirectly as pre-coated release liners called transfer tape.
In flame foam lamination, a flame front is used to attach the foam to scrim fabric, vinyl etc. Flame lamination is utilized primarily when combining foam to another material. The heat melts the surface of the foam, turning it into a tacky substance that essentially acts as an adhesive. That surface is then combined with another material, such as a fabric, and the two goods are then bonded together under pressure.
For lamination purpose the PU foam material must meet specific hardness/softness, flexibility and fire-safety requirements. Springfeel’s lamination grade foams have fine and uniform cell structure which gives excellent bonding strength.
The Main Applications
Automotive Seat Covers & Doors.
Footwear.
Thermal insulation.
Packaging.
Leather Goods. (Jackets, Gloves & Bags).
Helmet & Sports goods. (Lining)
HVAC.
Sports goods.
Healthcare.
Technical Specification
Latex feel foam is a good alternative to latex and it has a very fine cell structure and therefore highly-flexible.
Latex feel foam is mainly used as comfort layers in mattresses and pillows. They are used in mattresses for high load capacity (up to 140 kg).
This foam can be also used as comfort layer in high-end furniture.
Latex feel foam is absolutely hypo-allergenic, odorless, and the open-cell structure ensures good air circulation.
The Main Applications
Mattress Toppers
Furniture Lining
Pillows
Quilting
Technical Specification
The purpose of flexible polyurethane foam in packaging is to act as a shock absorber, protecting a moving packaged object from damage as it meets resistance, slows and finally comes to rest. Whether you need to protect a moderately heavy piece of equipment, or a delicate electronic component – the physical performance of polyurethane foam can be fine-tuned to meet most packaging needs. Two physical properties of flexible polyurethane foam are keys to packaging performance, namely firmness and density. IFD (Indentation Force Deflection) is the good indicator of the measurement for firmness. Density is a measurement of unit weight per volume in kg/m3 which naturally influences the hysteresis of a foam, that can absorb the impact energy.
Springfeel offers tailor-made solutions for packing, display and transporting the finished product and to ensure it is presented in the very best possible way. Several years of experience in designing and producing foam inserts for high quality manufacturers, we understand the need to ensure protection, provide functionality, add flair and value to your products.
In the low-cost disposable foam packing segment, we offer wide range of choice such as low-density foam, reconstituted (Re-bonded) chip foam and foam sheets cut to specific shapes/sizes.
Special grades like “Antistatic (ESD) foam & Fire Retardant foams” are also provided for packing and transporting highly specialized products such as computer parts, electronic goods and glassware etc
The Main Applications
Protecting delicate and lightweight objects.
Abrasion Resistant.
For packaging electronics and shipping sensitive instruments
Technical Specification
Coir mattresses manufacturers, in addition to their existing consumption of regular polyurethane foam, also want cost effective alternatives with high load bearing properties
In order to meet their requirements, we at Springfeel manufacture re-bonded polyurethane foam in densities like 80, 100 and 120 (in kg/m3). This re-bonded foam offers a more durable and effective solution to the use of traditional substances such as coir sheets and provides the mattress manufacturers the choice of either replacing the entire coir core or replacing a part of the coir core depending on availability, cost and other considerations.
Apart from the mattress industry re-bonded foam also finds use in the automobile industry and auxiliary power generating equipment as an effective sound dampening and vibration filtering material. The high compressive load bearing property of re-bonded enables it to be used as an ideal, cost effective underlay in the carpet industry.
Re-bonded foams are made from polyurethane foam chips with special additives and bonded under mechanical pressure to make the Re-bonded foam block and it is durable, strong and versatile.
Re-bond foam characteristics
The quality of rebounded foam depends on several factors like:
The types and grades of the foams used
The particle size and uniformity of the shredded foam pieces
The density required of the end product
The quality of the binder
The binder / foam ratio
Re-bonded foam properties can be varied over a wide range by careful selection of base material, particle size, compression ratio, type and quantity of the binder. As a consequence, re-bonded flexible foam is gaining acceptance in applications which so far could not be satisfied by virgin foam material.
The Main Applications
Orthopedic and regular mattress.
Acoustic & Sound Absorption.
Vibration Filters.
GYM & Sports Flooring.
Carpet underlay.
Packaging industry.
Technical Specification
As the name suggests, to cater to the demand of premier furniture manufacturers, a very soft grade of foam in the density range of 23 to 40 kg/m3 is manufactured. This is made possible by the addition of special foam modifiers which also enhance the foam properties apart from imparting soft feel of the foam. Super soft foam works best in comfort applications and is highly compactable.
When the goal is to increase comfort, super soft foam performs wonderfully as backing for furniture and as extra padding atop mattresses to soften and relieve pressure. Super soft foams are used for all quilting needs, mattress overlay, top lining in sofas, pillows, office bags, baby carrier bags, jackets, gloves etc.
The Main Applications
Quilting
Pillow
Mattress Covers & Toppers
Technical Specification
Polyurethane foam turns yellow as they age. The yellowing results from an oxidation in backbone of the polymer. Since it is the polymer itself that is being oxidized, the yellow color cannot be extracted. The foam which has turned yellow due to oxidation has similar properties to that of white foam. (Prior to oxidation).
Polyurethane foams are made by reacting a diisocynate with polyols and water. The isocyanate, typically Toluene diisocyanate (TDI) or Methylene diisocyanate (MDI), reacts with the polyol to form the urethane polymer. It also reacts with the water to release carbon dioxide.
The carbon dioxide acts as the blowing agent to form the cellular structure. The other product of the water/isocyanate reaction is an amine. This resulting aromatic amine will oxidize when exposed to UV light and oxygen to form a quinone. Quinones are yellow. They impart an increasing yellow hue to the foam as oxidation proceeds over time.
Since the quinone is a component of the urethane backbone, the yellow color cannot be extracted from the foam. The slight color change does not represent significant foam degradation.
UV absorbers protect against photo degradation by competing with polymer for absorption of ultraviolet light.
Light protecting agents/stabilizers can be added to the foam formulation at the manufacturing stage to aid in the delay of the yellowing process.
These additives can be split into two groups (UVA & HALS)
A. Ultraviolet Absorbers (UVA) – these function by absorbing harmful ultra violet radiation and dissipating it as thermal energy. An ideal UVA should be very light stable and should have high absorption over the UV range from 290 to 400 nanometers.
B. Hindered Amine Light Absorbers (HALS) – these represent an alternative chemistry in light stabilization technology. It does not absorb ultra violet radiation but acts as radical scavenger to inhibit degradation of the polymer. Due to the fact that HALS regenerate active stabilizer, moieties during the stabilization process they provide better long term light stability than UVA’s.
Springfeel’s UV grade foam provides high stability to light which is obtained by means of special additives. It is environment friendly and meets ROHS and REACH standards.
UV resistance is defined as the ability of a material to resist ultra violet (UV) light or sunlight. UV light or Sunlight, will cause the surface of the non-resistant materials to fade or discolor.
The UV accelerated weathering tester reproduces the damage caused by sunlight in a few days or weeks; this damage is equal to the damage which may be caused over a period of months or years in outdoors.
The samples, placed at a distance of 20 cm from a Xenon lamp (550W, Black standard temperature 70 C for 2 hrs) which reproduces the solar spectrum, are exposed to light in a conditioned cabinet (55 ° C, 85% RH) for 24 h. The color change of the samples in terms of Grey Scale Index of 1 to 5 is then determined.
The Main Applications
Footwear & Sports Shoes
Bra Cups, Inner wear & Lingerie
Garments & Jackets
Swim Suits
Technical Specification
Visco elastic foam or Memory foam is a sophisticated product that consistently recovers its original shape following compression.
This type of foam responds to heat, increasing its flexibility with increasing temperature. In this way, the foam takes the heat of the body and adapts to its shape, giving adequate and complete support to the entire surface.
Developed by NASA under the brand name Canfor foam in the 1980s, it was then launched into the wider market in the 1990s, when it was known as Visco-Elastic foam. It is now widely recognized as memory foam, which is primarily used in mattresses and pillows.
Springfeel’s Visco foam is on par with international standards. The Visco foam has a very unique soft feel due to its special properties. Its recovery time is between 5 to 7 seconds and resilience is less than 20%. These properties make it a popular choice in the home furnishing Segment.
The products made with Visco foam generally are Pillows, Mattress toppers, Sandwich mattresses, Sofa, Cushions, Bolsters, Chair pads etc. We make Visco foam is 40 and 65 kgs/m3.
FEATURES OF MEMORY FOAM
i.Temperature Sensitivity
They respond to pressure and temperature. It softens in reaction to your body heat. However, each product and composition has varying degrees of temperature sensitivity. The more sensitive the foam is, the more it will soften and hug’ your body and can contour to each individual’s body shape by reacting to the body temperature.
ii. Response Time
When pressure is applied to memory foam, it softens and takes the shape of the body. After the pressure is removed, it takes time for the foam to return to its original state. This response time depends on many factors such as composition, the rate of elasticity, variable viscosity, and resilience.
iii. Durability
Durability is an important factor to consider, no matter what product you are using. In the case of memory foam, durability is directly dependent on density.
The Main Applications
Mattresses Toppers.
Sandwich Mattress.
Mattress Quilting Layer.
Furniture & Sofa Cushions.
Pillows
Neck Rest
Technical Specification
